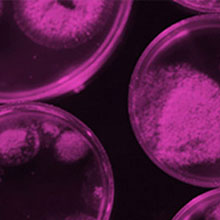
Tweet card summary image

Jessica Blair
@JessicaMABlair
Followers
9K
Following
26K
Media
401
Statuses
8K
Professor of Antimicrobial Resistance. Institute of Microbiology and Infection, University of Birmingham. Editor in Chief of npj Antimicrobials and Resistance
Birmingham, UK.
Joined January 2012
Congratulations to Prof Ferenc Mueller and Prof Jessica Blair, who have been awarded two of the four sLoLa grants from @BBSRC. Their innovative projects will investigate gene expression and antibiotic resistance, pushing frontiers of bioscience discovery.
We're delighted that researchers from @unibirmingham have been awarded two of four prestigious grants available from @BBSRC to develop projects which have potential to lead to major new contributions to biological knowledge. @UoBmedicalsci @UoBinfectionsch
https://t.co/puSGq0deOT
0
1
5
We're delighted that researchers from @unibirmingham have been awarded two of four prestigious grants available from @BBSRC to develop projects which have potential to lead to major new contributions to biological knowledge. @UoBmedicalsci @UoBinfectionsch
https://t.co/puSGq0deOT
0
2
6
Longitudinal study finds antibiotics and chemicals that drive resistance detected in an urban river system at levels that select for AMR 💊 https://t.co/hlbqtXvFEI
nature.com
npj Antimicrobials and Resistance - Environmental hazards from pollution of antibiotics and resistance-driving chemicals in an urban river network from Malawi
0
1
5
Find a home for your next publication in one of our open collections:
0
1
2
Plasmid survival strategies and mega plasmids found in wastewater treatment plant effluent 🚰 https://t.co/iwjg4lxmGm
nature.com
npj Antimicrobials and Resistance - Communities of plasmids as strategies for antimicrobial resistance gene survival in wastewater treatment plant effluent
0
2
7
Ever thought about how bacterial purine metabolism can affect the efficacy of antibiotics? Learn more in this review ⬇️ https://t.co/rCoL6bfEFK
nature.com
npj Antimicrobials and Resistance - The impact of bacterial purine metabolism on antibiotic efficacy
0
3
4
Overcoming extreme hydrophobicity for a promising clinical candidate for multidrug resistant Gram-positive infections 💉 https://t.co/xUF0JpuFmF
nature.com
npj Antimicrobials and Resistance - Pharmacokinetic and pharmacodynamic studies of injectable nocathiacin as a novel antibacterial agent
0
3
4
New preprint of my first corresponding author research paper! This is the result of my master students and some lovely collaborators! ☺️
Strain-dependent contribution of the AcrAB-TolC efflux pump to Klebsiella pneumoniae physiology https://t.co/bOCl9SYd9K
#biorxiv_micrbio
0
3
15
Strain-dependent contribution of the AcrAB-TolC efflux pump to Klebsiella pneumoniae physiology https://t.co/bOCl9SYd9K
#biorxiv_micrbio
biorxiv.org
Klebsiella pneumoniae is a prominent opportunistic pathogen increasingly associated with multidrug resistance and virulence. One of the main mechanisms of antimicrobial resistance in K. pneumoniae is...
0
5
9
Do digital antimicrobial 💊 prescribing apps help with clinical decision making? Check out the below evaluation published in @npjAMR 👇 https://t.co/PrGm8ewQoJ
nature.com
npj Antimicrobials and Resistance - A mixed methods evaluation of an antimicrobial prescribing clinical decision support system app
0
4
9
New paper out in Pneumonia. More data from the carriage study in Southampton, UK looking at pneumococci in pre-PCV13 era versus early- and late-PCV13 periods (I also snuck in some bits on other bacteria ... just for a bit of variety) https://t.co/prjdIDU8pc
pneumonia.biomedcentral.com
1
5
12
Assistant Prof post in bacterial genomics @unibirmingham ! Come and join us! https://t.co/mfnaoQ03wn
jobs.ac.uk
0
8
14
We are recruiting Editors to join Access Microbiology! We are looking to appoint Editors to play a vital role, ensuring the publication of high-quality research and fostering engagement within the Microbiology community. Find out more and apply here:
microbiologysociety.org
0
8
16
A potential antimicrobial treatment for Mycobacterium tuberculosis from a repurposed drug: https://t.co/J6B05Ihmdu
nature.com
npj Antimicrobials and Resistance - The Parkinson’s drug benztropine possesses histamine receptor 1-dependent host-directed antimicrobial activity against Mycobacterium tuberculosis
0
7
12
Meet the new spiked dinosaur rewriting the rulebook 🦖 Hear more about this spiky tank of a dinosaur from Prof Richard Butler who co-led the expedition with Dr Susannah Maidment from @NHM_London👇 https://t.co/2ygk2Sl89B
1
82
298
How can hospital sinks facilitate the spread of AMR?🚰 Find out more in this review published in @npjAMR: https://t.co/gnKadl3l8h
nature.com
npj Antimicrobials and Resistance - The hospital sink drain microbiome as a melting pot for AMR transmission to nosocomial pathogens
0
6
21
🚨 Job alert 🚨 I’m recruiting two postdoctoral research associates to join my lab at @KCLImmunoMicro to study how K. pneumoniae regulates virulence factor expression during infection! Mol Micro: https://t.co/KKuFJ8Xyo5 Infection: https://t.co/J8USdQvvM8 Deadline: 21st Sept.
0
29
44
A significant update for Acinetobacter AMR plasmid typing 📚🔍 https://t.co/8ASPIhFqfu
nature.com
npj Antimicrobials and Resistance - Pan-genus analysis and typing of antimicrobial resistance plasmids in Acinetobacter
0
7
17
Recent work shows within-city variation between food centre microbiomes and that these environments are enriched in antimicrobial resistance genes compared to other non-clinical city environments 🏙️🍴 https://t.co/LxcYbOlwLQ
nature.com
npj Antimicrobials and Resistance - Citywide metagenomic surveillance of food centres reveals local microbial signatures and antibiotic resistance gene enrichment
0
6
13